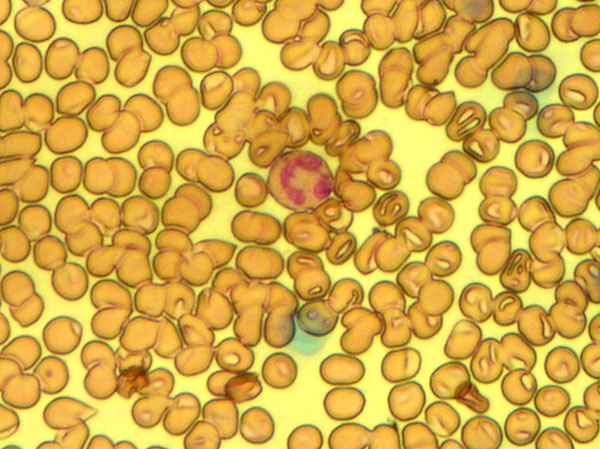
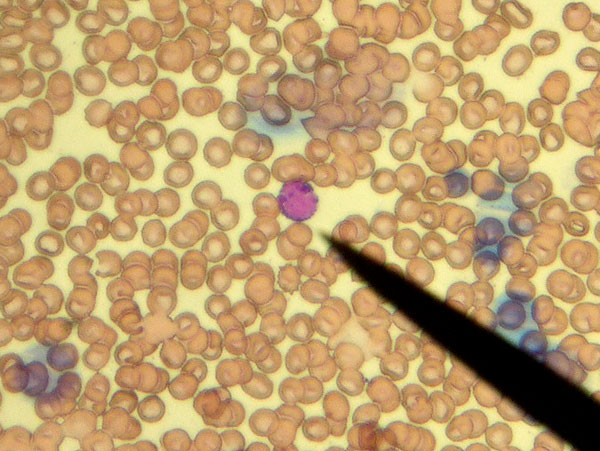

信息分類:站內(nèi)新聞
作者:yiyi發(fā)布
時間:2012-5-19 0:50:44
將本頁加入收藏
下一篇:血球形態(tài)判讀血液抹片制作方法-蓋玻片法優(yōu)點和缺點!金相顯微鏡價格
上一篇:細菌的生長與氧氣的關(guān)系和細菌的分裂生殖!金相顯微鏡價格
點擊查看產(chǎn)品參數(shù)和報價--丨--
---
---
---
正文:

合作伙伴: